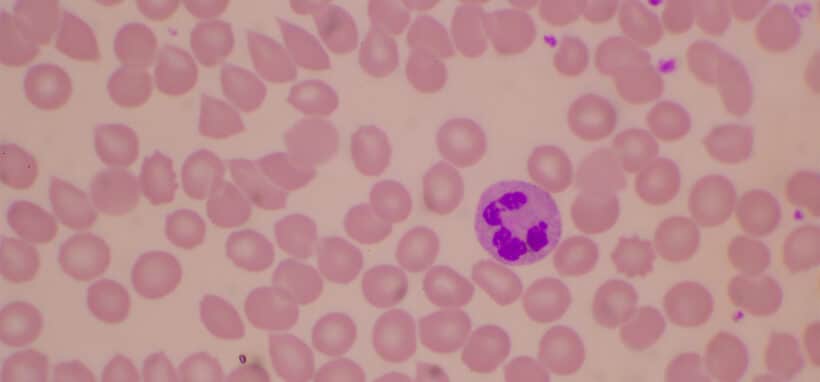

annebilir.com : annelerin buluşma noktası
annebilir.com’da hamilelik hazırlık süreci, hamilelik periyodu, yeni doğan bebek bakımı ve çocukların yaş dönemlerinde ihtiyaç duyabileceği hemen pek çok bilgiye rahatlıkla ulaşabilirsin. Annebilir olarak hayatının en değerli varlığı olan bebeğin için ihtiyaç duyabileceğin önemli bilgileri sana sunmak için özenle çalışıyoruz. Değişen jenerasyona göre yenilenen makaleler ebeveynliğe dair ihtiyaç duyabileceğin pek çok bilgiyi sana sunar. annebilir.com’da annelerin çok sık sorduğu soruların cevaplarına, ihtiyaç duydukları eşya ve ürünlerin artı ya da eksi olarak değerlendiren özelliklerine kısaca anneliğe dair her şeye yer verilir.
Hamilelik Dönemi İhtiyaçları
Annebilir.com hamilelik öncesi yapman gerekenlerden hamilelik boyunca geçireceğin süreçlere kadar her dönemde senin yanında. İhtiyaç duyabileceğin ve merak ettiğin sorularının cevaplarından derlenen içerikler ile kendini bu sürece tam ve hazır hissedebilirsin. Makaleler içinde; hamilelik dönemi ihtiyaçlarına, baby shower etkinliklerine ,sağlıklı beslenmeye, gebelik dönemi yoğa ve pilates ihtiyaçlarına, doğum fotoğraf bilgilerine kadar her konuya uzun uzun yer verilir. Böylece hayatının önemli ve keyifli dönemlerinden biri olan hamilelik sürecini donanımlı bir şekilde tamamlayabilirsin. Gebelik hem fiziksel hem de psikolojik olarak kendini hazır hissetmen gereken bir süreç olduğundan bu dönemde kendini geliştirerek hamileliğe ve anne olmaya zamanını adayabilirsin.
Yenidoğan Bebek Bakımı
Sadece anne adayları için değil bebek bakımına dair de aradığın pek çok bilgiyi Annebilir.com’da kolaylıkla bulabilirsin. Hamilelik sürecini başarıyla tamamlamış ve bebekli yeni bir hayata giriş yapmış olabilirsin. Hiç endişe duymana gerek yok. Annebilir bebek bakım sürecinde de senin yanında. Hem anneliği ilk kez deneyimleyen hem de deneyimi anneler için döneme göre yenilenen ve gelişen bebek bakım ürünlerinden en değerli varlığın büyürken ihtiyaç duyabileceği eşyalara kadar merak ettiğiniz her şeyi sitede bulabilirsin. Yeni doğan bebeklerde çok sık görülen rahatsızlar, her daim ihtiyaç olan bebek mobilya ve eşyalarının avantaj sağlayan model seçenekleri gibi faydalı içeriklere ulaşabilirsin. Ayrıca yeni doğan bebek bakımıyla ilgili içeriklerde emzirme dönemi, diş buğdayı, hamilelik sonrası spor gibi farklı bilgiler hakkında da merak edebileceğin pek çok bilgiye ulaşabilirsin.
1-6 Yaş Dönemi
Bebeklikten çocuk döneme geçerken de ebeveynlerin kendilerini geliştirmeye devam etmesi gerekir. Çocukluğun en önemli dönemleri arasında yer alan 1-6 yaş aralığında öğrenmek isteyeceğin pek çok konu hakkında bilgi sahibi olabilirsin. Çocuk bakım hizmeti, oyun saati ve süreleri, oyuncak seçimi, spor dönemi, müzik ve sanatsal faaliyetler gibi çocuğunun gelişimini olumlu yönde destekleyen unsurlar hakkında fikir sahibi olabilir ve hemen uygulamaya geçebilirsin. 1-6 yaş döneminde kardeş ilişkileri, çocukların bu süreçte yaşadıkları psikolojik zorluklar hakkında detaylı bilgilere Annebilir’de seni bekler. Günden güne büyüyen ve gelişen annebilir.com ihtiyacın olan bilgileri sana sunar. Bilgilendirme amaçlı keyifli içerikler ile kendini geliştirebilir, deneyimlerini zenginleştirebilirsin. Annelik hiç bitmeyen bir sorumluluktur, Annebilir.com bu süreçte hep yanında.